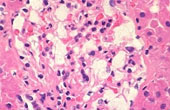

患者様が直接診察を受ける場所ではありませんが、お一人おひとりの現在の状態を正確に捉え、最適な治療を行うための「羅針盤」としての役割を担っています。
医師の指示に基づき、体内のさまざまな情報をデータ化することを「臨床検査」と呼びます。
当科では、国家資格を持つ6名の臨床検査技師が、高度な専門知識と技術をもってこれらの検査を担当しています。
検査データは、病気の診断、治療方針の決定、治療効果の確認、そして病気の早期発見のために欠かせない情報です。
生体情報(身体やその一部である血液、尿、便、痰など)を用いて検査データとして報告し、医師が病気の診断や治療方針の決定、治療効果の判定、病気の 早期発見などをするお手伝いをしています。
患者様からお預かりした大切な検体や生体情報を一つひとつ丁寧に扱い、正確なデータを提供できるよう日々努力を重ねております。
検査のことで不安なことや疑問があれば、検査の際などにどうぞお気軽にお声がけください。
検体検査

- 細胞診検査
-
がん検診を受けましょう
細胞診検査とは、いろいろな検査材料(婦人科材料・腹水・胸水・尿・喀痰など)で異型(悪性)細胞がないかどうかを確認する検査です。細胞以外にもウイルス感染の有無や炎症など治療に役立つ情報を提供します。

- 血液学検査
-
貧血や熱、痛みはありませんか?
血液の成分である赤血球にヘモグロビン、白血球や血小板を計って貧血や炎症、血液疾患の診断に役立てます。

- 生化学検査
-
血液のコレステロール(善玉・悪玉)の値に注意していますか?
血液などの成分量を測って身体の異常を発見します。 糖・脂肪(コレステロール・中性脂肪など)ミネラル・ホルモン・ 酵素(GOT、γ‐GTPなど・・)腫瘍マーカー等、血液中の酸素や二酸化炭素の量も測定します。
- 免疫血清学検査
-
発熱・呼吸症状。肺炎・胃腸炎の原因を探します。
進入してきた外敵を患者さんの免疫機能(血清など)や検体を使って探します。(細菌・ウイルス・アレルゲンなど)血液型や輸血適合 検査をし輸血の副作用を回避します。 自己免疫疾患もこの検査です。

- 微生物検査
-
下痢・咳や痰・熱発・化膿・痛みは感染症(微生物)が原因かも!!
検体から細菌を培養し、病原菌を見つけ出したり、寄生虫を探します。

- 一般検査
-
採尿は患者さんの負担が少なく情報いっぱい。採血はやっぱり痛いし嫌いですよね!
尿や便、髄液の成分を調べて異常を発見します。糖や蛋白、出血や髄膜炎などを検査します。

- その他の検査
-
組織や細胞を検査し病気の診断や癌細胞を探す補助もします。
生理学検査
生理学検査では患者さんの身体から測定機器を使って直接情報を読み取ります。

- 心電図検査
-
動悸・めまい・胸痛・目の前真っ暗…もしかしたら心臓疾患?
心臓系の検査です。胸や手足に電極付けて検査します。標準12誘導や負荷心電図、24時間ホルター心電図などがあります。

- 肺機能検査
-
息を吸って吸って…吐いて吐いて…の検査です。いい息してますか?
肺の検査で呼吸機能検査とも言われます。大きな呼吸をしてその量や速さを測ります。肺活量やフローボリュームなどの検査があります。

- 脳波検査
-
脳波はベッドで寝ながら検査します。お昼寝してください!
頭に電極を付けて電気的信号を記録します。

- 神経生理検査
-
電気刺激はちょっと痛くてごめんなさい。
手や足を電気刺激したり、音を聞いてその伝導速度や波形を記録します。 手や足のしびれ、神経や聴力の検査です。

- その他血圧脈波検査
-
血管の硬さや詰まりがないか検査します。
設備















